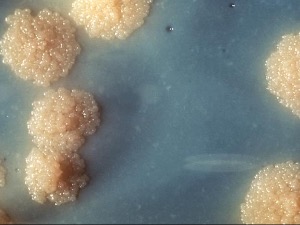
Сто година од бесеже вакцине

Наука
субота, 27. мар 2021, 18:25 -> 18:50
Дешавања на Сунцу
Сунце је за нас постојана, спокојна визија вечности. Првога дана септембра 1859. енглески астроном Ричард Карингтон забележио је знакове турбуленције на површини наше звезде. Био је то почетак једне од...
субота, 27. мар 2021, 08:50 -> 09:24
Интуиција потиче из стомака, тврде научници
Што је више микроба у цревима неке особе, већа је вероватноћа да ће бити интуитивна, кажу истраживачи који су желели да додају научну тежину том необичном „осећају у стомаку“ које неке људе наводи да доносе...
петак, 26. мар 2021, 14:02 -> 14:32
Мирис и укус
Губитак чула мириса (аносмија) и смањени или изгубљени осећај укуса (агеузија) симптоми су који су описани у већини земаља током пандемије коронавируса. Услед блиске функционалне активности два хемосензорна...
четвртак, 25. мар 2021, 08:40 -> 12:48
Жене су биле владарке и у бронзаном добу
Раскошни предмети пронађени у гробу из бронзаног доба у Шпанији сведоче да је тамо сахрањена владарка, што се коси са идејом да су у том периоду владали само мушкарци...
среда, 24. мар 2021, 20:57 -> 21:09
Највећа птица на свету имала је необично велики мозак, а најсличнији савремени рођак јој је - кокошка
Неретко се, као увреда може чути да неко има „птичји мозак“, али, највећа птица нелетачица, која је насељавала нашу планету, имала је главу пречника око пола метра, која јој је пружала доста простора за...
среда, 24. мар 2021, 09:19 -> 09:01
Сто година од бесеже вакцине
Пре него што су настале вакцине, свет је био веома опасно место за живот. Милиони људи су умирали од болести које данас, захваљујући вакцинама, могу да се спрече. Бeсеже (BCG) вакцина против туберкулозе...
среда, 24. мар 2021, 09:00 -> 09:09
Велики Шигирски идол, најстарија дрвена статуа на свету, дупло старија од Стоунхенџа
Шигирски идол, тотем висок 2,80 метара, састављен од 10 делова украшених геометријским резбаријама и импознатим људским лицима, најстарија је дрвена скулптура на свету и једини преживели дрвени артефакт...
уторак, 23. мар 2021, 20:59 -> 21:04
Осетљивост врхова наших прстију је већа но што смо могли и да помислимо
Кожа - највећи орган људског дела – обавија нас од главе до пете и омогућава нам да путем додира осетимо и комуницирамо са спољним светом. Али постоји један део тог органа који је најосетљивији на додир...
уторак, 23. мар 2021, 15:21 -> 15:27
Клауд сервиси и трансформација пословања
Kомпаније које данас желе да успешно послују у свакој индустрији, морају константно унапређивати услуге, сервисе и пословне стратегије, као и развијати способности да исте, што брже и ефикасније, презентују...
уторак, 23. мар 2021, 14:48 -> 15:03
Златне маске и свила стара 3.000 година, пронађени у јамама за жртвовање у Кини
У провинцији Сечуан, на познатом археолошком налазишту, пронађени су предмети од бронзе, злата и слоноваче, који могу да помогну у расветљавању мистериозне историје цивилизације Шу...

Коментари